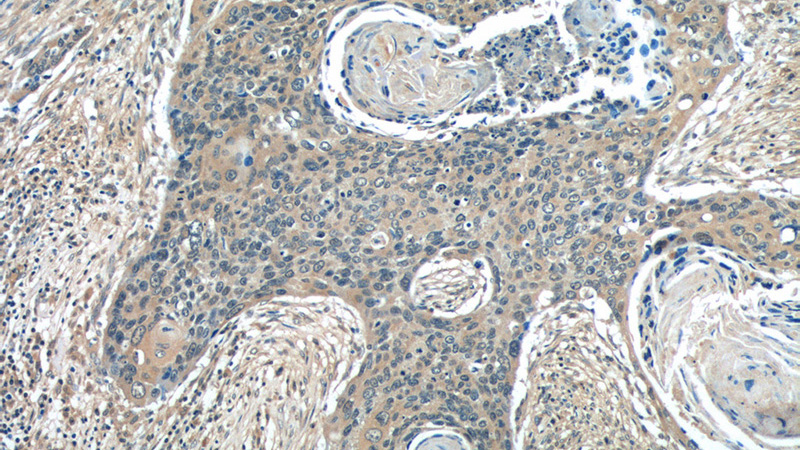
Immunohistochemistry of paraffin-embedded human cervical cancer tissue slide using Catalog No:115479(SNX27 Antibody) at dilution of 1:50 (under 10x lens)

-
Product Name
SNX27 antibody
- Documents
-
Description
SNX27 Rabbit Polyclonal antibody. Positive WB detected in Jurkat cells. Positive IHC detected in human cervical cancer tissue, human tonsillitis tissue. Observed molecular weight by Western-blot: 52-60kd
-
Tested applications
ELISA, WB, IHC
-
Species reactivity
Human,Mouse,Rat; other species not tested.
-
Alternative names
KIAA0488 antibody; MRT1 antibody; MY014 antibody; SNX27 antibody; Sorting nexin 27 antibody; sorting nexin family member 27 antibody
-
Isotype
Rabbit IgG
-
Preparation
This antibody was obtained by immunization of SNX27 recombinant protein (Accession Number: BC012184). Purification method: Antigen affinity purified.
-
Clonality
Polyclonal
-
Formulation
PBS with 0.02% sodium azide and 50% glycerol pH 7.3.
-
Storage instructions
Store at -20℃. DO NOT ALIQUOT
-
Applications
Recommended Dilution:
WB: 1:500-1:5000
IHC: 1:20-1:200
-
Validations

Jurkat cells were subjected to SDS PAGE followed by western blot with Catalog No:115479(SNX27 antibody) at dilution of 1:1200
Immunohistochemistry of paraffin-embedded human cervical cancer tissue slide using Catalog No:115479(SNX27 Antibody) at dilution of 1:50 (under 10x lens)

Immunohistochemistry of paraffin-embedded human cervical cancer tissue slide using Catalog No:115479(SNX27 Antibody) at dilution of 1:50 (under 40x lens)
-
Background
Sorting nexin 27 (SNX27), a PDZ domain-containing protein, belongs to the sorting nexin family of proteins. SNX27 promotes recycling of internalized transmembrane proteins from endosomes to the plasma membrane by linking PDZ-dependent cargo recognition to retromer-mediated transport (PMID: 21602791; 23563491). It has been shown that SNX27 deficiency contributes to the synaptic and cognitive deficits by modulating glutamate receptor recycling in Down’s syndrome (PMID: 23524343). SNX27 has also been proposed to have a role in regulating β-amyloid (Aβ) generation by modulating γ-secretase activity, which is a molecular mechanism for Aβ-dependent pathogenesis in both Down’s syndrome and Down’s syndrome (PMID: 25437557).
Related Products / Services
Please note: All products are "FOR RESEARCH USE ONLY AND ARE NOT INTENDED FOR DIAGNOSTIC OR THERAPEUTIC USE"
